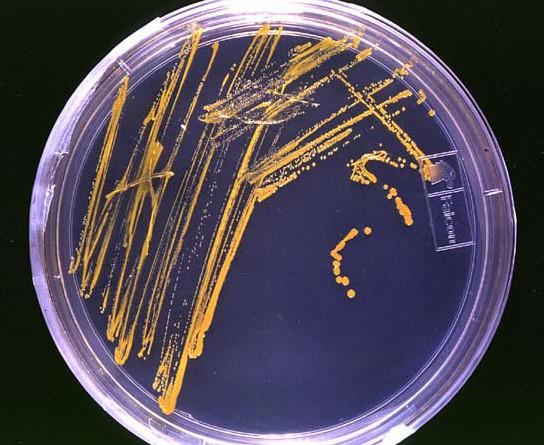
výroba

Proteiny
Created by Dominika Vagundová
Myšlenková mapa proteinů.

Aminokyselina

Peptidový řetězec

struktura

Protein

21 esenciálních AMK
člověk si je neumí vyrobit
změna struktury bílkovin
osamostatnění proteinů
oslabena interakce protein-voda
izoelektrický bod
donor/akceptor elektronu
působení vnějších podmínek
změna teploty, pH...
koagulace
srážení - způsobené roztoky
vratná změna

denaturace

molekuly vody přitahovány k iontům soli
pevné

nevratná změna
ztráta fce bílkoviny
metoda separace bílkovin
vysolování

aneb jak zbavit protein vody?
Vznik
omezeně rozpustné ve vodě

Vlastnosti
př. vaření vajec
rozklad proteinu
Reakce

vznik proteinu
Alfa-helix

Primární

kondenzace
spojení skupiny karboxylové a aminové
Beta-skládaný list

Sekundární
Struktura
Proteiny

transportní

vznik peptidické vazby
katalytická

Terciární

Funkce
regulační

nerozpustné ve vodě
Fibrální

Kvartérní

Výroba
stavební materiál
skleroproteiny
Globurální

Dělení
stavební

sféroproteiny
rozpustné ve vodě
oligopeptidy
20-10 AMK
proteiny
100 a více
GMO
např. inzulin
kolagen

polypeptidy
10-100 AMK
keratin

globuliny

obranné

histony

albuminy

Zástupci
složené bílkoviny
peptidové hormony
oxytocin, ADH, inzulin aj...
glutathion
opravář
detoxikace
jednoduché bílkoviny
fosfoproteiny
esterově vázaná kys. fosforečná
kasein

glykoproteiny
sekret sliznic

hemoproteiny
